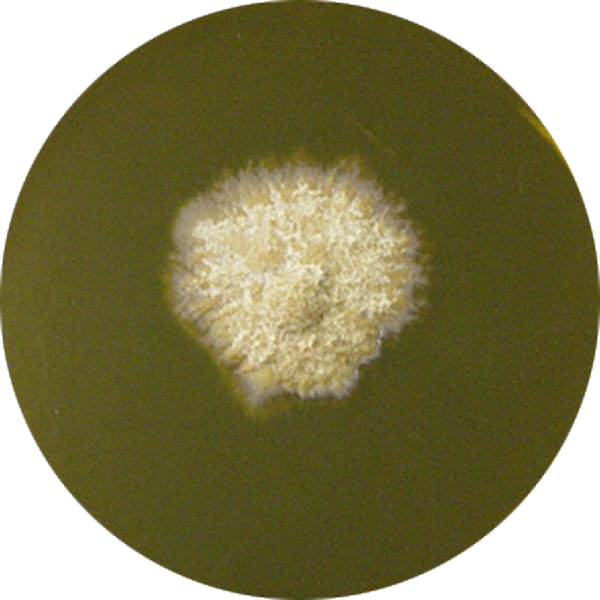
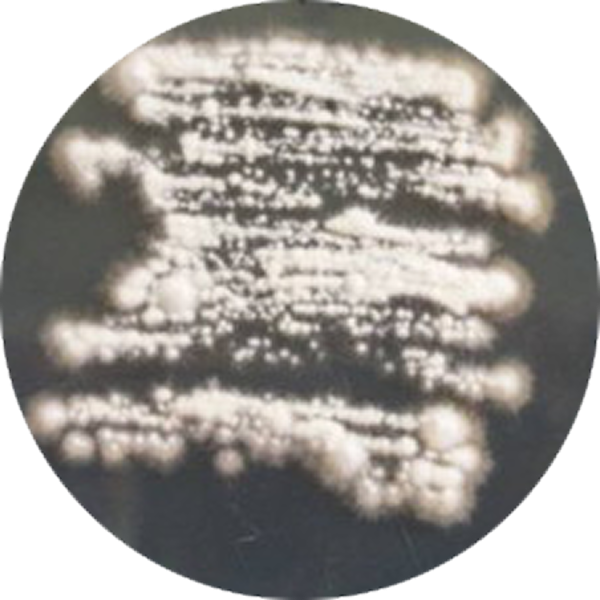

Селективна культуральна
тест-система для діагностики грибкових захворювань InTray® DM
тест-система для діагностики грибкових захворювань InTray® DM
МОЖЛИВОСТІ ТЕСТА «InTRAY DM Medium»:
- Проста ідентифікація характерної морфології, що супроводжується зміною кольору середовища з жовтого на червоний;
- Легке спостереження процесу інкубації через оптичне вікно, що не запітніє;
- Унікальний дизайн та склад тесту знижує ризик мікробної контамінації;
- Стабільний склад середовища з терміном придатності до 27 місяців;
- Ви не потребуєте термостату (інкубація при кімнатній температурі від 18°С до 25°С);
- Інгібує зростання грампозитивних та грамнегативних бактерій;
- Проста ідентифікація характерної морфології, що супроводжується зміною кольору середовища з жовтого на червоний;
- Легке спостереження процесу інкубації через оптичне вікно, що не запітніє;
- Унікальний дизайн та склад тесту знижує ризик мікробної контамінації;
- Стабільний склад середовища з терміном придатності до 27 місяців;
- Ви не потребуєте термостату (інкубація при кімнатній температурі від 18°С до 25°С);
- Інгібує зростання грампозитивних та грамнегативних бактерій;